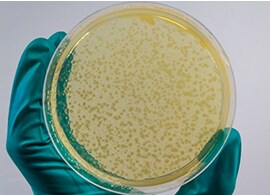
Six Considerations for Competent Cell Selection Scientist’s gloved hand holding up a tube of competent cells above ice

Search
Search
A bacterial strain is defined as a subgroup of a bacterial species with specific genetic variations from the parental wild type. Competent cells derived from E. coli strains are predominantly used in transformation experiments. Most common strains used for transformation include DH5α, BL21, HB101, and JM109. Each strain can be described by its genotype, which lists mutations, e.g., insertions and deletions (Figure 1). The genotype of an E. coli strain is an important aspect of competent cells in that it determines whether the cells can be grown on specific media or resistant to antibiotic, the suitability of transformation with specific DNA (e.g., unstable repeats or methylated), and compatibility of cloning strategies.
The functions and phenotypes of genes are sometimes suggested by their three-letter symbols in the genotype. Related genes are distinguished by an uppercase letter following the three-letter code, e.g., lacY and lacZ for two of the genes of the lac operon. Phenotypic identifications are sometimes included in the genotype as unitalicized letters starting with a capital letter (e.g., TetR for tetracycline resistance of the INV110 strain; see Figure 1).
Figure 1. Genotype of bacterial strain INV110. An example of how genotypes of bacterial strains are written and how to read them.
Figure 2. Examples of bacterial genetic markers and their impacts. (A) tonA prevents infection by T1 bacteriophage (colored green). (B)lacZΔM15 enables screening of positive (white) and negative (blue) colonies. (C) endA prevents degradation of plasmid (manifested as gel smears) during isolation.
The E. coli strains used in transformation can be broadly classified based on application. Detailed list of strains per application is described:
| Bacterial strain | Genotype |
|---|---|
| BL21-AI | F–ompT hsdSB (rB–, mB–) gal dcm araB::T7RNAP-tetA |
| BL21(DE3) | F–ompT hsdSB (rB–, mB–) gal dcm (DE3) |
| BL21(DE3)pLysS | F–ompT hsdSB (rB–, mB–) gal dcm (DE3) pLysS(CamR) |
| BL21(DE3)pLysE | F–ompT hsdSB (rB–, mB–) gal dcm (DE3) pLysE(CamR) |
| BL21 Star(DE3) | F–ompT hsdSB (rB–, mB–) gal dcm rne131 (DE3) |
| BL21 Star(DE3)pLysS | F–ompT hsdSB (rB–, mB–) gal dcm rne131 (DE3) pLysS(CamR) |
| ccdB Survival 2 | F–mcrA Δ(mrr-hsdRMS-mcrBC) φ80lacZΔM15 ΔlacX74 recA1 araΔ139 Δ(ara-leu)7697 galU galK rpsL(StrR) endA1 nupG fhuA::IS2 |
| DH5α | F– φ80lacZΔM15 Δ(lacZYA-argF)U169 recA1 endA1 hsdR17(rK–, mK+) phoA supE44 λ–thi-1 gyrA96 relA1 |
| DH5α-E | F– φ80lacZΔM15 Δ(lacZYA-argF)U169 recA1 endA1 hsdR17(rK–, mK+) gal–phoA supE44 λ–thi-1 gyrA96 relA1 |
| DH5α-T1R | F– φ80lacZΔM15 Δ(lacZYA-argF)U169 recA1 endA1 hsdR17 (rK–, mK+) phoA supE44 λ–thi-1 gyrA96 relA1 tonA |
| DH5αF′IQ | F′φ80lacZΔM15 Δ(lacZYA-argF)U169 recA1 endA1 hsdR17 (rK–, mK+) phoA supE44 λ–thi-1 gyrA96 relA1/F′ [proAB+lacIqZΔM15 zzf::Tn5(KmR)] |
| DH10B | F–mcrA Δ(mrr-hsdRMS-mcrBC) φ80lacZΔM15 ΔlacX74 recA1 endA1 araD139 Δ(ara-leu)7697 galU galK λ–rpsL(StrR) nupG |
| DH10B T1R | F–mcrA Δ(mrr-hsdRMS-mcrBC) φ80lacZΔM15 ΔlacX74 recA1 endA1 araD139 Δ(ara-leu)7697 galU galK λ–rpsL(StrR) nupG tonA |
| DH10Bac | F–mcrA Δ(mrr-hsdRMS-mcrBC) φ80lacZΔM15 ΔlacX74 recA1 endA1 araD139 Δ(ara-leu)7697 galU galK λ–rpsL nupG / bMON14272 / pMON7124 |
| DH12S | φ80ΔlacZΔM15 mcrA Δ(mrr-hsdRMS-mcrBC) araD139 Δ(ara-leu)7697 Δ(lacX74 galU galK rpsL(StrR) nupG recA1 / F′ [proAB+lacIqZΔM15 Tn10(TetR)] |
| INV110 | F′ [traD36 proAB lacIqlacZΔM15] rpsL (StrR) thr leu endA thi-1 lacY galK galT ara tonA tsx dam dcm supE44 Δ(lac-proAB) Δ(mcrC-mrr)102::Tn10(TetR) |
| INVαF′ | F′ endA1 recA1 hsdR17 (rK–, mK+) supE44 thi-1 gyrA96 relA1 φ80lacZΔM15 Δ(lacZYA-argF)U169 λ– |
| Mach1 T1R | F– φ80lacZΔM15 ΔlacX74 hsdR(rK–, mK+) ΔrecA1398 endA1 tonA |
| MC1061/P3 | F–hsdR(rK–, mK+) araD139 Δ(araABC-leu)7679 galU galK ΔlacX74 rpsL(StrR) thi mcrB / P3: KanR AmpR (am) TetR (am) |
| OmniMAX 2 T1R | F′ [proAB+lacIqlacZΔM15 Tn10(TetR) Δ(ccdAB)] mcrA Δ(mrr-hsdRMS-mcrBC) φ80lacZΔM15 Δ(lacZYA-argF)U169 endA1 recA1 supE44 thi-1 gyrA96 (NalR) relA1 tonA panD |
| PIR1 | F–∆lac169 rpoS(am) robA1 creC510 hsdR514 endA recA1 uidA(∆MluI)::pir-116 |
| PIR2 | F–∆lac169 rpoS(am) robA1 creC510 hsdR514 endA recA1 uidA(∆MluI)::pir |
| Stbl2 | F–mcrA Δ(mcrBC-hsdRMS-mrr) recA1 endA1 lon gyrA96 thi supE44 relA1 λ– Δ(lac-proAB) |
| Stbl3 | F–mcrB mrr hsdS20(rB–, mB–) recA13 supE44 ara-14 galK2 lacY1 proA2 rpsL20(StrR) xyl-5 λ–leu mtl-1 |
| Stbl4 | mcrA Δ(mcrBC-hsdRMS-mrr) recA1 endA1 gyrA96 gal–thi-1 supE44 λ–relA1 Δ(lac-proAB) / F′ [proAB+lacIqZΔM15 Tn10(TetR)] |
| TOP10 | F–mcrA Δ(mrr-hsdRMS-mcrBC) φ80lacZΔM15 ΔlacX74 recA1 araD139 Δ(ara-leu)7697 galU galK λ–rpsL(StrR) endA1 nupG |
| TOP10F′ | F′ [lacIq, Tn10(TetR)] mcrA Δ(mrr-hsdRMS-mcrBC) φ80lacZΔM15 ΔlacX74 recA1 araD139 Δ(ara-leu)7697 galU galK rpsL(StrR) endA1 nupG |
| TOP10/P3 | F–mcrA Δ(mrr-hsdRMS-mcrBC) φ80lacZΔM15 ΔlacX74 recA1 araD139 Δ(ara-leu)7697galU galK rpsL(StrR) endA1 nupG λ– / P3: KanR AmpR (am) TetR (am) |
| Genetic marker | Description, phenotype, or benefit |
|---|---|
| (am) |
|
| AmpR (also written ApR) |
|
| ara-14 araB araD139 |
|
| Δ(ara-leu)7697 |
|
| argF |
|
| bMON14272 |
|
| CamR (also written CmR) |
|
| ccdAB |
|
| creC510 (also called phoM) |
|
| dam |
|
| dcm |
|
| (DE3) |
|
| endA endA1 |
|
| F– |
|
| F+, F′, or Hfr |
|
| fhuA (also known as tonA) |
|
| gal gal- |
|
| galK |
|
| galU |
|
| gyrA96 |
|
| hsdRMS hsdS20 hsdR514 hsdR17 hsdSB |
|
| IS2 |
|
| KanR (also called KmR) |
|
| λ– |
|
| lacIq |
|
| lacY |
|
| ∆lacX74 | |
| Δ(lacZYA-argF)U169 (also called ΔlacZU169) |
|
| lacZ∆M15 |
|
| leu |
|
| lon |
|
| mcrB mcrBC mrr |
|
| mtl-1 |
|
| NalR |
|
| nupG |
|
| ompT |
|
| φ80 |
|
| P3 |
|
panD |
|
| phoA |
|
| pir pir-116 |
|
| pLys pLysE |
|
| pMON7124 |
|
| proAB |
|
| recA1 recA13 recA1398 |
|
| relA1 |
|
| RNAP |
|
| rne131 |
|
| robA1 |
|
| rpoS |
|
| rpsL rpsL20 |
|
| StrR (also written SmR) |
|
| supE(44) (also called glnV44) |
|
| TetR (also written TcR) |
|
| thi-1 thi |
|
| thr |
|
| Tn5 (KmR) |
|
| Tn10 (TetR) |
|
| tonA (also called fhuA) |
|
| traD36 |
|
| tsx |
|
| uidA(∆MluI) |
|
| xyl-5 |
|
| zzf::Tn5 |
|
| Bacterial strain | Genotype |
|---|---|
| BL21-AI | F–ompT hsdSB (rB–, mB–) gal dcm araB::T7RNAP-tetA |
| BL21(DE3) | F–ompT hsdSB (rB–, mB–) gal dcm (DE3) |
| BL21(DE3)pLysS | F–ompT hsdSB (rB–, mB–) gal dcm (DE3) pLysS(CamR) |
| BL21(DE3)pLysE | F–ompT hsdSB (rB–, mB–) gal dcm (DE3) pLysE(CamR) |
| BL21 Star(DE3) | F–ompT hsdSB (rB–, mB–) gal dcm rne131 (DE3) |
| BL21 Star(DE3)pLysS | F–ompT hsdSB (rB–, mB–) gal dcm rne131 (DE3) pLysS(CamR) |
| ccdB Survival 2 | F–mcrA Δ(mrr-hsdRMS-mcrBC) φ80lacZΔM15 ΔlacX74 recA1 araΔ139 Δ(ara-leu)7697 galU galK rpsL(StrR) endA1 nupG fhuA::IS2 |
| DH5α | F– φ80lacZΔM15 Δ(lacZYA-argF)U169 recA1 endA1 hsdR17(rK–, mK+) phoA supE44 λ–thi-1 gyrA96 relA1 |
| DH5α-E | F– φ80lacZΔM15 Δ(lacZYA-argF)U169 recA1 endA1 hsdR17(rK–, mK+) gal–phoA supE44 λ–thi-1 gyrA96 relA1 |
| DH5α-T1R | F– φ80lacZΔM15 Δ(lacZYA-argF)U169 recA1 endA1 hsdR17 (rK–, mK+) phoA supE44 λ–thi-1 gyrA96 relA1 tonA |
| DH5αF′IQ | F′φ80lacZΔM15 Δ(lacZYA-argF)U169 recA1 endA1 hsdR17 (rK–, mK+) phoA supE44 λ–thi-1 gyrA96 relA1/F′ [proAB+lacIqZΔM15 zzf::Tn5(KmR)] |
| DH10B | F–mcrA Δ(mrr-hsdRMS-mcrBC) φ80lacZΔM15 ΔlacX74 recA1 endA1 araD139 Δ(ara-leu)7697 galU galK λ–rpsL(StrR) nupG |
| DH10B T1R | F–mcrA Δ(mrr-hsdRMS-mcrBC) φ80lacZΔM15 ΔlacX74 recA1 endA1 araD139 Δ(ara-leu)7697 galU galK λ–rpsL(StrR) nupG tonA |
| DH10Bac | F–mcrA Δ(mrr-hsdRMS-mcrBC) φ80lacZΔM15 ΔlacX74 recA1 endA1 araD139 Δ(ara-leu)7697 galU galK λ–rpsL nupG / bMON14272 / pMON7124 |
| DH12S | φ80ΔlacZΔM15 mcrA Δ(mrr-hsdRMS-mcrBC) araD139 Δ(ara-leu)7697 Δ(lacX74 galU galK rpsL(StrR) nupG recA1 / F′ [proAB+lacIqZΔM15 Tn10(TetR)] |
| INV110 | F′ [traD36 proAB lacIqlacZΔM15] rpsL (StrR) thr leu endA thi-1 lacY galK galT ara tonA tsx dam dcm supE44 Δ(lac-proAB) Δ(mcrC-mrr)102::Tn10(TetR) |
| INVαF′ | F′ endA1 recA1 hsdR17 (rK–, mK+) supE44 thi-1 gyrA96 relA1 φ80lacZΔM15 Δ(lacZYA-argF)U169 λ– |
| Mach1 T1R | F– φ80lacZΔM15 ΔlacX74 hsdR(rK–, mK+) ΔrecA1398 endA1 tonA |
| MC1061/P3 | F–hsdR(rK–, mK+) araD139 Δ(araABC-leu)7679 galU galK ΔlacX74 rpsL(StrR) thi mcrB / P3: KanR AmpR (am) TetR (am) |
| OmniMAX 2 T1R | F′ [proAB+lacIqlacZΔM15 Tn10(TetR) Δ(ccdAB)] mcrA Δ(mrr-hsdRMS-mcrBC) φ80lacZΔM15 Δ(lacZYA-argF)U169 endA1 recA1 supE44 thi-1 gyrA96 (NalR) relA1 tonA panD |
| PIR1 | F–∆lac169 rpoS(am) robA1 creC510 hsdR514 endA recA1 uidA(∆MluI)::pir-116 |
| PIR2 | F–∆lac169 rpoS(am) robA1 creC510 hsdR514 endA recA1 uidA(∆MluI)::pir |
| Stbl2 | F–mcrA Δ(mcrBC-hsdRMS-mrr) recA1 endA1 lon gyrA96 thi supE44 relA1 λ– Δ(lac-proAB) |
| Stbl3 | F–mcrB mrr hsdS20(rB–, mB–) recA13 supE44 ara-14 galK2 lacY1 proA2 rpsL20(StrR) xyl-5 λ–leu mtl-1 |
| Stbl4 | mcrA Δ(mcrBC-hsdRMS-mrr) recA1 endA1 gyrA96 gal–thi-1 supE44 λ–relA1 Δ(lac-proAB) / F′ [proAB+lacIqZΔM15 Tn10(TetR)] |
| TOP10 | F–mcrA Δ(mrr-hsdRMS-mcrBC) φ80lacZΔM15 ΔlacX74 recA1 araD139 Δ(ara-leu)7697 galU galK λ–rpsL(StrR) endA1 nupG |
| TOP10F′ | F′ [lacIq, Tn10(TetR)] mcrA Δ(mrr-hsdRMS-mcrBC) φ80lacZΔM15 ΔlacX74 recA1 araD139 Δ(ara-leu)7697 galU galK rpsL(StrR) endA1 nupG |
| TOP10/P3 | F–mcrA Δ(mrr-hsdRMS-mcrBC) φ80lacZΔM15 ΔlacX74 recA1 araD139 Δ(ara-leu)7697galU galK rpsL(StrR) endA1 nupG λ– / P3: KanR AmpR (am) TetR (am) |
| Genetic marker | Description, phenotype, or benefit |
|---|---|
| (am) |
|
| AmpR (also written ApR) |
|
| ara-14 araB araD139 |
|
| Δ(ara-leu)7697 |
|
| argF |
|
| bMON14272 |
|
| CamR (also written CmR) |
|
| ccdAB |
|
| creC510 (also called phoM) |
|
| dam |
|
| dcm |
|
| (DE3) |
|
| endA endA1 |
|
| F– |
|
| F+, F′, or Hfr |
|
| fhuA (also known as tonA) |
|
| gal gal- |
|
| galK |
|
| galU |
|
| gyrA96 |
|
| hsdRMS hsdS20 hsdR514 hsdR17 hsdSB |
|
| IS2 |
|
| KanR (also called KmR) |
|
| λ– |
|
| lacIq |
|
| lacY |
|
| ∆lacX74 | |
| Δ(lacZYA-argF)U169 (also called ΔlacZU169) |
|
| lacZ∆M15 |
|
| leu |
|
| lon |
|
| mcrB mcrBC mrr |
|
| mtl-1 |
|
| NalR |
|
| nupG |
|
| ompT |
|
| φ80 |
|
| P3 |
|
panD |
|
| phoA |
|
| pir pir-116 |
|
| pLys pLysE |
|
| pMON7124 |
|
| proAB |
|
| recA1 recA13 recA1398 |
|
| relA1 |
|
| RNAP |
|
| rne131 |
|
| robA1 |
|
| rpoS |
|
| rpsL rpsL20 |
|
| StrR (also written SmR) |
|
| supE(44) (also called glnV44) |
|
| TetR (also written TcR) |
|
| thi-1 thi |
|
| thr |
|
| Tn5 (KmR) |
|
| Tn10 (TetR) |
|
| tonA (also called fhuA) |
|
| traD36 |
|
| tsx |
|
| uidA(∆MluI) |
|
| xyl-5 |
|
| zzf::Tn5 |
|